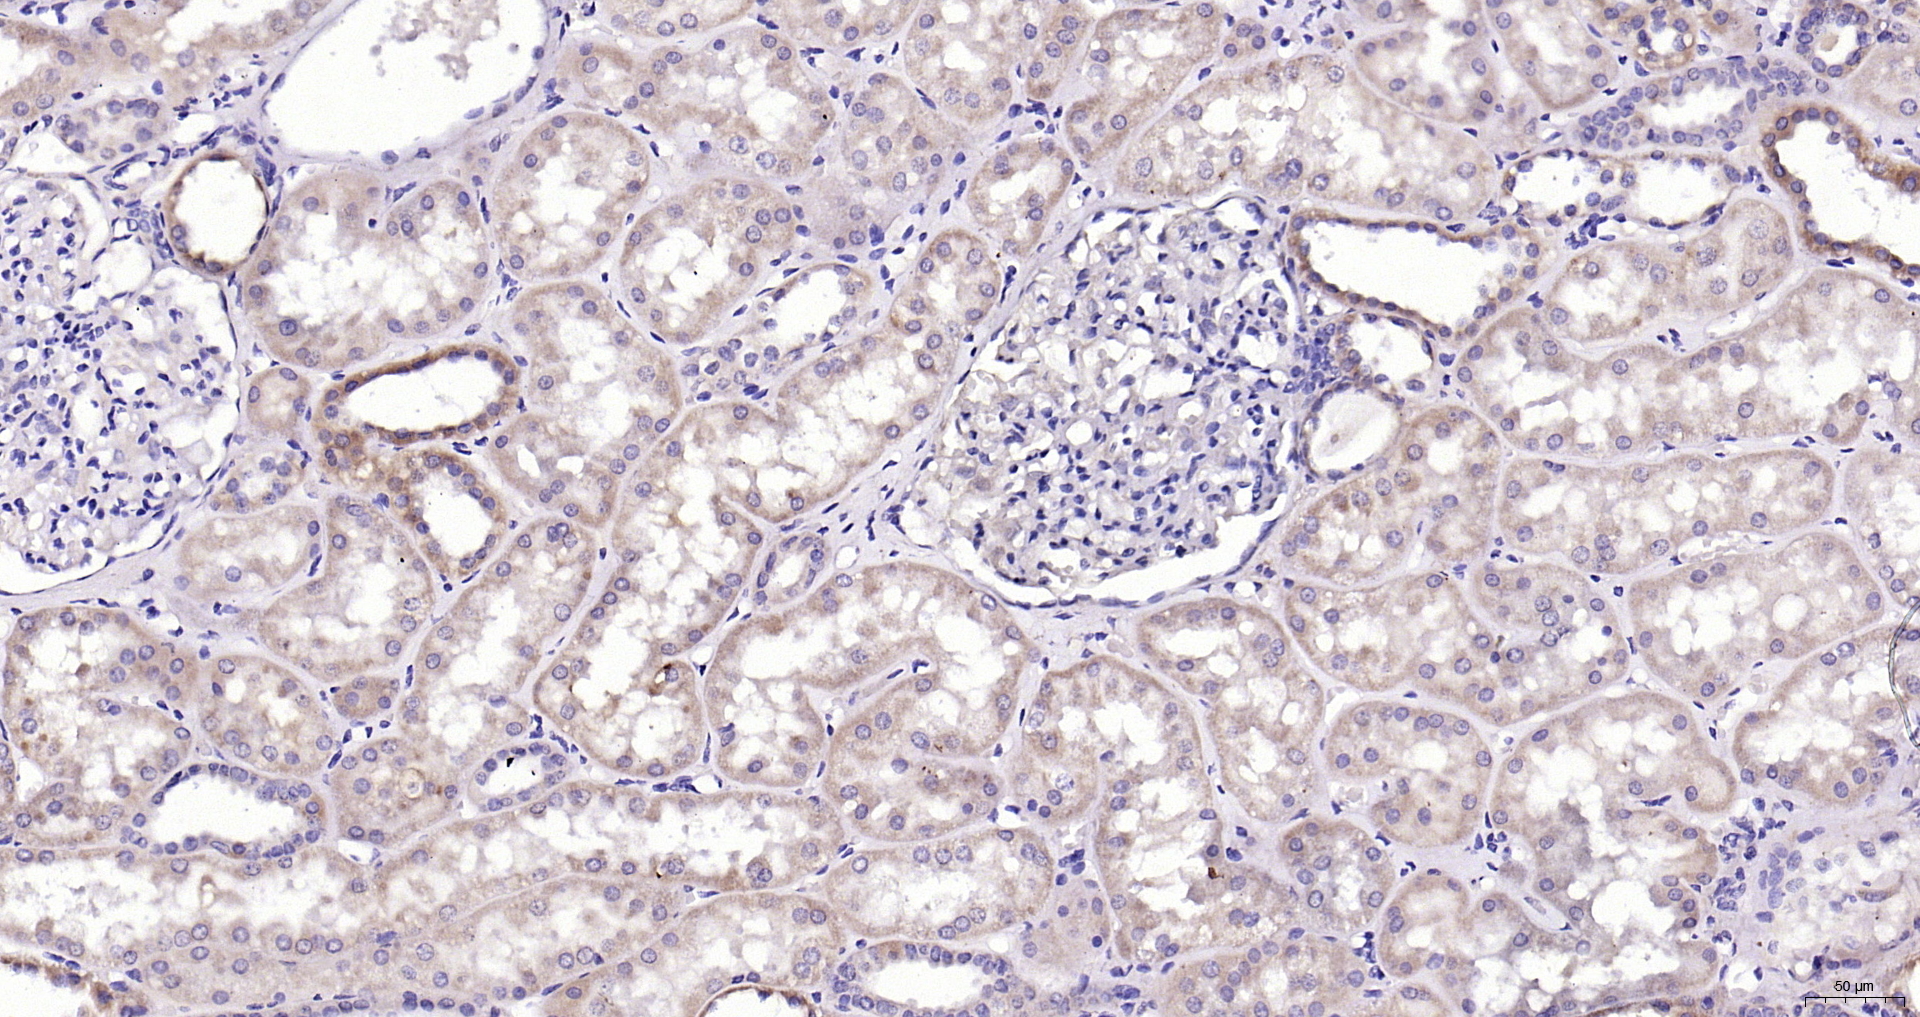
Paraformaldehyde-fixed, paraffin embedded (Human kidney); Antigen retrieval by boiling in sodium citrate buffer (pH6.0) for 15min; Block endogenous peroxidase by 3% hydrogen peroxide for 20 minutes; Blocking buffer (normal goat serum) at 37°C for 30min; Antibody incubation with (CaMKII (Thr286)) Polyclonal Antibody, Unconjugated (bs-1647R) at 1:400 overnight at 4°C, followed by operating according to SP Kit(Rabbit) (sp-0023) instructionsand DAB staining. Paraformaldehyde-fixed, paraffin embedded (Human kidney); Antigen retrieval by boiling in sodium citrate buffer (pH6.0) for 15min; Block endogenous peroxidase by 3% hydrogen peroxide for 20 minutes; Blocking buffer (normal goat serum) at 37°C for 30min; Antibody incubation with (CaMKII (Thr286)) Polyclonal Antibody, Unconjugated (bs-1647R) at 1:400 overnight at 4°C, followed by operating according to SP Kit(Rabbit) (sp-0023) instructionsand DAB staining.

Formalin-fixed and paraffin embedded rat brain labeled with Anti-Phospho-CaMKII (Thr286) Polyclonal Antibody, Unconjugated (bs-1647R) at 1:200 followed by conjugation to the secondary antibody and DAB staining.
Phospho-CaMKII (Thr287) Polyclonal Antibody
BS-1647R
ApplicationsWestern Blot, ELISA, ImmunoHistoChemistry, ImmunoHistoChemistry Paraffin
Product group Antibodies
ReactivityChicken, Human, Mouse, Rabbit, Rat, Sheep
TargetCamk2a
Overview
- SupplierBioss
- Product NamePhospho-CaMKII (Thr287) Polyclonal Antibody
- Delivery Days Customer16
- ApplicationsWestern Blot, ELISA, ImmunoHistoChemistry, ImmunoHistoChemistry Paraffin
- Applications SupplierWB(1:300-5000), ELISA(1:500-1000), IHC-P(1:200-400)
- CertificationResearch Use Only
- ClonalityPolyclonal
- Concentration1 ug/ul
- ConjugateUnconjugated
- Gene ID12322
- Target nameCamk2a
- Target descriptioncalcium/calmodulin-dependent protein kinase II alpha
- Target synonymsCaMKII, mKIAA0968, calcium/calmodulin-dependent protein kinase type II subunit alpha, CaMK II, alpha-CaMKII, caM kinase II subunit alpha, caMK-II subunit alpha
- HostRabbit
- IsotypeIgG
- Protein IDP11798
- Protein NameCalcium/calmodulin-dependent protein kinase type II subunit alpha
- ReactivityChicken, Human, Mouse, Rabbit, Rat, Sheep
- Storage Instruction-20°C
- UNSPSC12352203
References
- Tang Q, Ke H, Wu C, et al. Aqueous extract from You-Gui-Yin ameliorates cognitive impairment of chronic renal failure mice through targeting hippocampal CaMKIIα/CREB/BDNF and EPO/EPOR pathways. J Ethnopharmacol. 2019,239:111925. doi: 10.1016/j.jep.2019.111925Read this paper